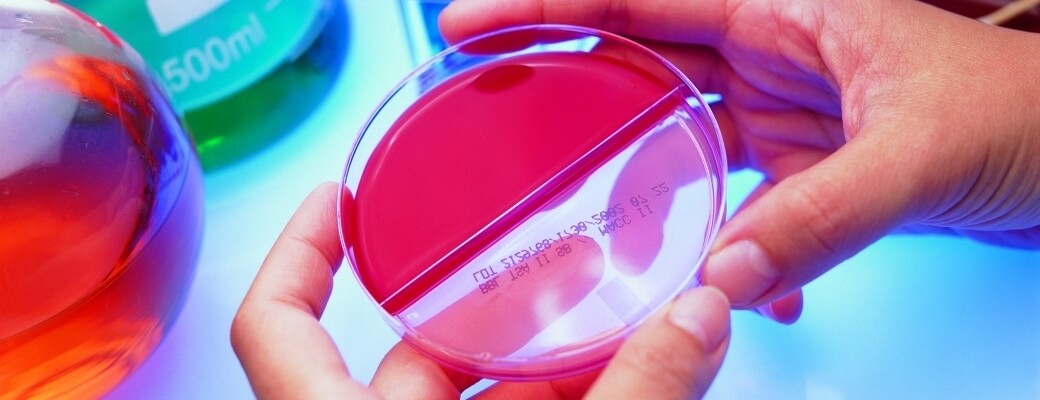

Laboratório Caarapó desde 1980 atendendo com qualidade!
LUZIA MILANI LOPES
CRF. 517/80
Farmacêutica-Bioquímica, formada pela UNIVERSIDADE ESTADUAL DE MARINGÁ, em 1.979.
Para sua maior comodidade e conforto, o Laboratório Caarapó realiza a coleta de material para exames também em sua residência. Optando pelo Atendimento Domiciliar você é atendido, no endereço de sua preferência, com a mesma cordialidade, qualidade e tecnologia que encontra nas unidades do Laboratório Caarapó.
As coletas em domicílio devem ser agendadas até às 17h do dia anterior à coleta através do telefone 3453 1457. Ao fazer a ligação tenha em mãos a requisição médica.